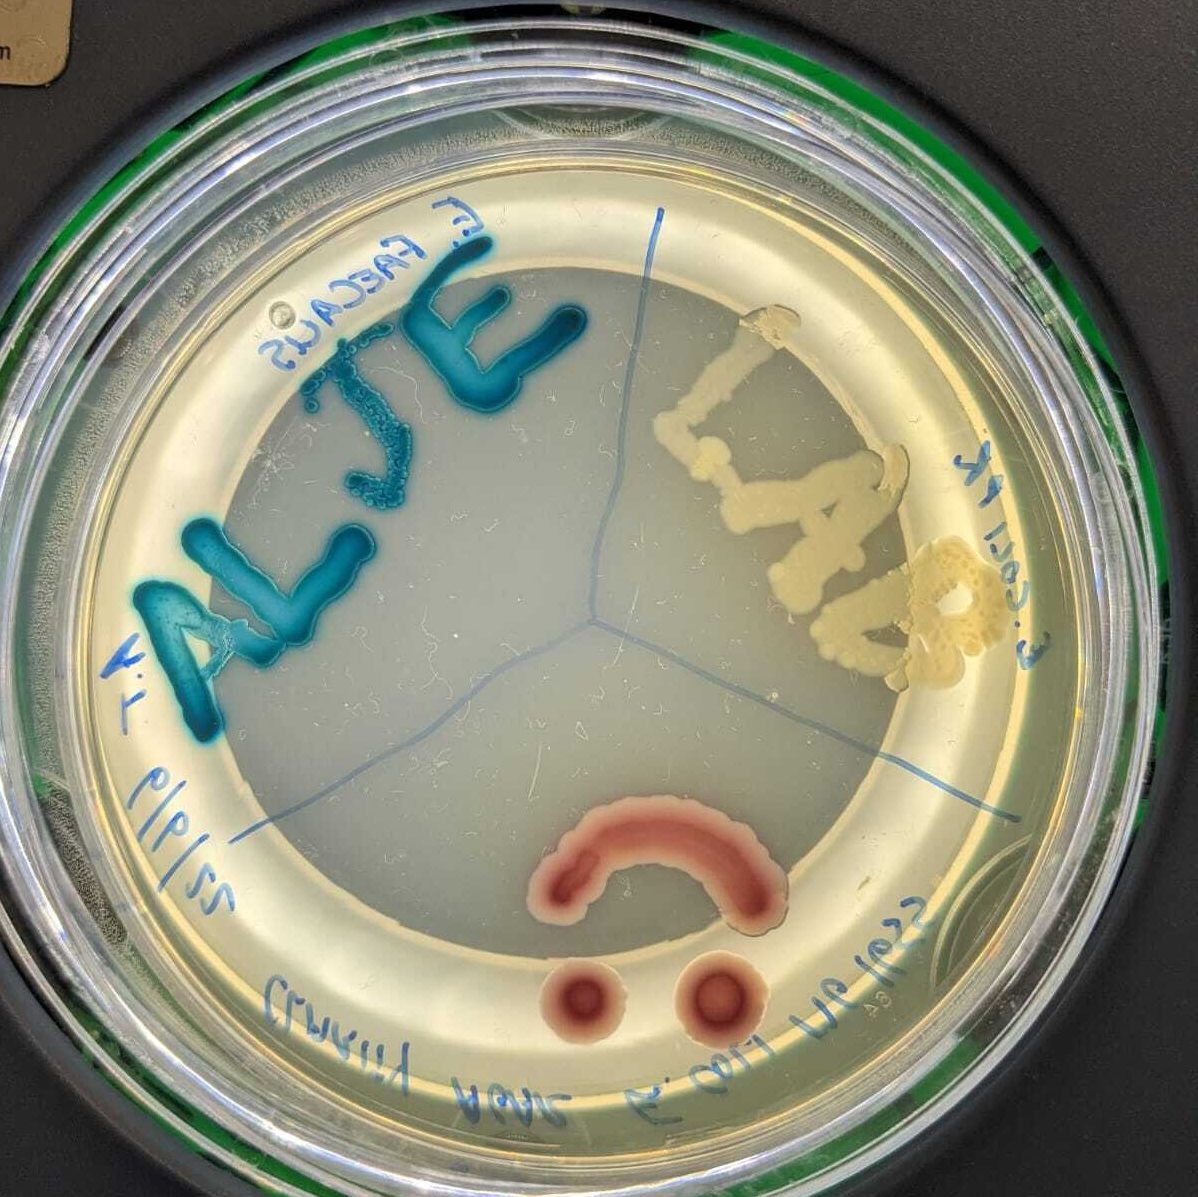

Note: We share our lab with Dr Andrew Letten whose group is also working on antibiotic resistance in bacteria but more from an ecological angle. Together we’re the ALJE lab (see recent artwork). Check out Andrew’s lab website as well: https://andrewletten.net.
Current lab members
Jan Engelstädter (PI)

I am an evolutionary biologist broadly interested in microbial evolution, currently focusing on antibiotic resistance evolution and gene exchange in bacteria. I use a combination of mathematical modelling and experimental work to address fundamental questions within this exciting field.
I did my PhD with Greg Hurst at University College London, working on the endosymbiotic bacterium Wolbachia. After postdoctoral positions at Harvard University (with David Haig) and ETH Zurich (with Sebastian Bonhoeffer) and a junior group leader position at ETH Zurich I moved to Australia to start my current position at The University of Queensland where I am now an Associate Professor. In addition to research I am actively involved in teaching into various courses on evolutionary biology and modelling, and I am the Director of the Master of Quantitative Biology program at UQ. I have been an Associate Editor for Evolution and I’m currently an Associate Editor for Proceedings B.
Links: Profile at UQ, Google Scholar, ORCID
Andrew Tuck (lab manager in Engelstaedter & Letten lab)

Andrew started his career in Science late in life, after reading and studying fields including nutrition, disease and ageing for several years. After obtaining a First-Class Honours Degree in Biochemistry, he has worked at various capacities across the Queensland Brain Institute, the Institute of Molecular Biosciences, and the School of Biological Sciences. For several years, he worked on the issue of the genetics of resistance to the fumigant gas phosphine in Paul Ebert’s lab in the School of Biological Sciences, where he helped to characterise resistance in the insect species Rhyzopertha dominicaand Tribolium castaneum, as well as the model organism Caenorhabditis elegans. During this time, he acquired the skills of Lab Management and Workplace Health and Safety, as well as helping to supervise and train over 28 PhD, Masters and Honours students.
Jack Price (PhD student)

I have previously worked on concepts such as cryptic genetic variation and the effects of environmental conditions on the adaptability of populations. I am now looking at how integrons behave in bacteria, both in respects to antibiotic resistance and also in a more general evolutionary sense. Hopefully I will be able to gain some insight into what impact these prevalent genetic systems are having on the evolutionary behaviour of bacterial populations. More generally, I am interested in the possibilities and constraints placed on evolving populations. What exactly evolution can deal with and what restricts its adaptive potential is what motivates me to further explore and learn about this fascinating phenomenon.
Elisha Freedman (PhD student)

I have been fascinated by the world of insect endosymbionts and their profound influence on the evolutionary trajectories of their hosts since learning about the well known endosymbiont, Wolbachia, in my undergraduate degree. Also working with Dr. Simone Bloomberg, and Associate Professor Lyn Cook, my research will be focusing on simulating infection multiplicities and the maintenance of these infections within insect host populations. I will also be looking into the endosymbiont infection patterns of scale insects that parasitize gum trees. I am interested in whether the relatedness and proximity of host plant species influences the patterns of endosymbiont infections across these scale insects.
Ian Gooi (PhD student)

Hello there. I’m Ian, a microbe and data wrangler interested in the predictability and repeatability of antibiotic resistance evolution. My work is based on the Gram-negative soil bacterium Acinetobacter baylyi, which I use as a model organism to understand evolutionary dynamics on a broader scale. Using a combination of experimental evolution and in-silico prediction, I explore both how A. baylyi evolves in response to antibiotic pressure, as well as the functional limits and challenges of trying to predict evolutionary trajectories from first principles. When I’m not in the lab, I’m also interested in (separately) sandwiches, tea, spiders, and Oxford commas.
Yuhan Zhu (Honours student)

Hi, I am Yuhan I am currently working on the mathematical modelling of antibiotic resistance evolution specifically in pharmacodynamics and its predictability. By using R to build a math model that uses the pharmacodynamic function and ODE model, we hope to know how predictable antibiotic resistance evolution can be. Besides studying and trying to work out how my code can be more efficient, I enjoy relaxing and petting my cat.
Oscar Delaney (Honours student)

I majored in genetics, maths, and philosophy in my science/arts dual degree in UQ, and am now working on computational modelling of antibiotic resistance evolution, considering recombination, resource constraints and population bottlenecks. Some of the key troubles with this approach are a) the real world isn’t as neat and tidy as our model, and b) even our model is sufficiently big and messy that results can be hard to interpret. However, I think these are surmountable barriers and that computer simulations are an interesting addition to lab and clinical work. And I think coding is pretty fun!
Joshua Bloomfield (Honours student & lab assistant)

Straight out of high school Josh knew exactly what he wanted to do with his life, theatre. After establishing himself in the Brisbane theatre scene, one of Josh’s friends lent him Sean B. Carroll’s The making of the fittest: DNA and the Ultimate Forensic Record of Evolution. He knew then the next logical step in his career, do a triple major with a focus on evolutionary science. Josh completed a Bachelor of Science and Art in 2021 having majored in Biochemistry, Psychology and Sociology.
Josh’s interest in evolutionary science drew him to work on a semester project with Jan and Andrew Letten. Now doing his honours under their joint supervision he is researching the interactions and competition between probiotic and pathogenic urinary tract bacteria. His research will help explore the usage of probiotics as an alternative treatment for urinary tract infection. Armed with a flair for the dramatic and a passion for science, Josh is eager to both research and communicate evolution and microbiology.
Alicia Williams (Lab assistant)

While completing my undergraduate degree in microbiology, I became fascinated by environmental microbiology and the role bacteria play in communities. For my Honours project, I am studying the fitness costs of antibiotic resistance mutations in E. coli under different resource regimes. My research will hopefully help to answer the fundamental question of how resistant and sensitive bacteria coexist in communities, which has numerous applications in ecology, agriculture and healthcare.
Co-supervised PhD students:
- Negin Bolourchi (primary supervisor: Andrew Letten)
- James Richardson (primary supervisor: Andrew Letten)
- Vishwa Patel (primary supervisor: Andrew Letten)
- Charles Zhou (primary supervisor: Daniel Ortiz-Barrientos)
- Angelique Asselin (primary supervisor: Karyn Johnson)
- Nick O’Brien (primary supervisor: Daniel Ortiz-Barrientos)
- Laura Baseggio (primary supervisor: Andy Barnes)
- Avneet Kaur (primary supervisor: Daniel Ortiz-Barrientos)
Alumni
PhD students
- Beth Brittain
- Ehsan Sanaei
(next stop: postdoc at Griffith University) - Nicole Fortuna
(next stop: postdoc at The University of Queensland) - Hasan “Shimul” Chowdhury Mehedi
(next stop: postdoc at the University of Liverpool, UK) - Danesh Mohadigaravand
(now Assistant Professor at King Abdullah University of Science & Technology)
Honours students
- Maddie Boggan
(next: Data Analyst at an insurance company) - Eric Roeed
(next stop: PhD student at The Norwegian University of Life Sciences) - Olivia Jessop (next: PhD student at The University of Queensland)
- Alan Sunil
- Mary Gannon
- James Reeve
(next stop: PhD student at the University of Gothenburg, Sweden) - Mark Chan: Honours student 2016
(next stop: PhD student at Nanyang Technological University, Singapore) - Nick Smith: Honours student 2014
(next stop: PhD student at the University of Sydney)
Lab managers and Lab assistants
- Verna Hearne
- James Reeve
- Angie Nguyen Vu
Some of our collaborators (present and past):
- Pia Abel zur Wiesch (The Arctic University of Norway & Yale University, USA)
- Sebastian Bonhoeffer (ETH Zurich, Switzerland)
- Sylvain Charlat (CNRS, University of Lyon, France)
- Lyn Cook (The University of Queensland, Australia)
- Olivier Duron (CNRS, University of Monpellier II, France)
- Dieter Ebert (University of Basel)
- Isabelle Gordo (Gulbenkian Institute of Science, Portugal)
- Fred Guillaume (ETH Zürich, Switzerland)
- David Haig (Harvard University, USA)
- Alex Hall (ETH Zürich)
- Peter Hammerstein (Humboldt University Berlin, Germany)
- Greg Hurst (University of Liverpool, UK)
- Pål Johnsen (University of Tromsø, Norway)
- Andrew Letten (The University of Queensland, Australia)
- Celine Loot (Pasteur Institute Paris, France)
- Rafal Mostowy (Imperial College London, UK)
- Daniel Ortiz-Barrientos (The University of Queensland, Australia)
- Mark Schembri (The University of Queensland, Australia)
- Arndt Telschow (University of Münster, Germany)
- Christoph Vorburger (ETH Zürich, Switzerland)